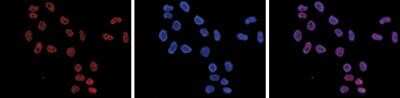

Histone H3 [Dimethyl Lys4] Antibody (C.15200151) - BSA Free
Novus Biologicals, part of Bio-Techne | Catalog # NBP2-59288

Key Product Details
Species Reactivity
Human, Fungi
Applications
Western Blot, ELISA, Immunocytochemistry/ Immunofluorescence, Chromatin Immunoprecipitation (ChIP)
Label
Unconjugated
Antibody Source
Monoclonal Mouse IgG1 Clone # C.15200151
Format
BSA Free
Concentration
Please see the vial label for concentration. If unlisted please contact technical services.
Product Specifications
Immunogen
The exact sequence of the immunogen to this Histone H3 [Dimethyl Lys4] antibody (C.15200151) is proprietary.
Modification
Dimethyl Lys4
Clonality
Monoclonal
Host
Mouse
Isotype
IgG1
Theoretical MW
15 kDa.
Disclaimer note: The observed molecular weight of the protein may vary from the listed predicted molecular weight due to post translational modifications, post translation cleavages, relative charges, and other experimental factors.
Disclaimer note: The observed molecular weight of the protein may vary from the listed predicted molecular weight due to post translational modifications, post translation cleavages, relative charges, and other experimental factors.
Description
Novus Biologicals Mouse Histone H3 [Dimethyl Lys4] Antibody (C.15200151) - BSA Free (NBP2-59288) is a monoclonal antibody validated for use in WB, ELISA, ICC/IF and ChIP. All Novus Biologicals antibodies are covered by our 100% guarantee.
Scientific Data Images for Histone H3 [Dimethyl Lys4] Antibody (C.15200151) - BSA Free
Western Blot: Histone H3 [Dimethyl Lys4] Antibody (C.15200151) [NBP2-59288] - Histone extracts (15 ug) from HeLa cells were analysed by Western blot using the antibody against H3K4me2 diluted 1:1,000 in TBS-Tween containing 5% skimmed milk. Observed molecular weight is ~16 kDa.
Immunocytochemistry/Immunofluorescence: Histone H3 [Dimethyl Lys4] Antibody (C.15200151) [NBP2-59288] - HeLa cells were stained with the antibody (left) diluted 1:500 in blocking solution followed by an anti-mouse antibody conjugated to Alexa Fluor 594. The middle panel shows staining of the nuclei with DAPI. A merge of the two stainings is shown on the right.
Chromatin Immunoprecipitation: Histone H3 [Dimethyl Lys4] Antibody (C.15200151) [NBP2-59288] - ChIP assays were performed using HeLa cells, the monoclonal antibody against H3K4me2 and optimized PCR primer sets for qPCR. Chromatin was sheared with the antibody consisting of 1, 5 and 10 ug per ChIP experiment was analysed. IgG (5 ug/IP) was used as negative IP control. QPCR was performed with primers for the promoter and the coding region of the GAPDH gene, and for the RPL10 and HBB promoters. Figure shows the recovery, expressed as a % of input (the relative amount of immunoprecipitated DNA compared to input DNA after qPCR analysis).
Applications for Histone H3 [Dimethyl Lys4] Antibody (C.15200151) - BSA Free
Application
Recommended Usage
Chromatin Immunoprecipitation (ChIP)
1 ug
ELISA
1:5000
Immunocytochemistry/ Immunofluorescence
1:500
Western Blot
1:1000
Formulation, Preparation, and Storage
Purification
Protein A purified
Formulation
PBS
Format
BSA Free
Preservative
0.05% Sodium Azide
Concentration
Please see the vial label for concentration. If unlisted please contact technical services.
Shipping
The product is shipped with polar packs. Upon receipt, store it immediately at the temperature recommended below.
Stability & Storage
Store at -20C. Avoid freeze-thaw cycles.
Background: Histone H3
Histones are nuclear proteins responsible for the nucleosome structure of the chromosomal fiber in eukaryotes. Changes in chromatin structure play a large role in the regulation of transcription. The chromatin fibers are compacted through the interaction of a linker histone, H1, with the DNA between the nucleosomes to form higher order chromatin structures.
Common histone modifications include methylation of lysine and arginine, acetylation of lysine, phosphorylation of threonine and serine, and sumoylation, biotinylation, and ubiquitylation of lysine. Posttranslational modifications such as acetylation of core histones regulates gene expression, thus altering protein function and regulation (1). Histone H3 is primarily acetylated at lysines 9, 14, 18, and 23 and have a theoretical molecular weight of 15 kDa. Acetylation at lysine 9 and 14 appears to control histone deposition, chromatin assembly and active transcription. Methylation of arginine residues within histone H3 has also been linked to transcription regulation. Histone H3 has been linked to various types of cancer as a biomarker through the aberrant expression of histone deacetylase (HDAC) enzymes and changes to chromatins (2-4).
References
1. Zhang, Y. X., Akumuo, R. C., Espana, R. A., Yan, C. X., Gao, W. J., & Li, Y. C. (2018). The histone demethylase KDM6B in the medial prefrontal cortex epigenetically regulates cocaine reward memory. Neuropharmacology, 141, 113-125. doi:10.1016/j.neuropharm.2018.08.030
2. Nandakumar, V., Hansen, N., Glenn, H. L., Han, J. H., Helland, S., Hernandez, K, ...Meldrum, D. R. (2016). Vorinostat differentially alters 3D nuclear structure of cancer and non-cancerous esophageal cells. Sci Rep, 6, 30593. doi:10.1038/srep30593
3. Zhou, M., Li, Y., Lin, S., Chen, Y., Qian, Y., Zhao, Z., & Fan, H. (2019). H3K9me3, H3K36me3, and H4K20me3 Expression Correlates with Patient Outcome in Esophageal Squamous Cell Carcinoma as Epigenetic Markers. Dig Dis Sci, 64(8), 2147-2157. doi:10.1007/s10620-019-05529-2
4. Li, Y., Guo, D., Sun, R., Chen, P., Qian, Q., & Fan, H. (2019). Methylation Patterns of Lys9 and Lys27 on Histone H3 Correlate with Patient Outcome in Gastric Cancer. Dig Dis Sci, 64(2), 439-446. doi:10.1007/s10620-018-5341-8
Alternate Names
H3F3A, H3K4Me2
Gene Symbol
H3C14
Additional Histone H3 Products
Product Documents for Histone H3 [Dimethyl Lys4] Antibody (C.15200151) - BSA Free
Product Specific Notices for Histone H3 [Dimethyl Lys4] Antibody (C.15200151) - BSA Free
This product is for research use only and is not approved for use in humans or in clinical diagnosis. Primary Antibodies are guaranteed for 1 year from date of receipt.
Loading...
Loading...
Loading...
Loading...